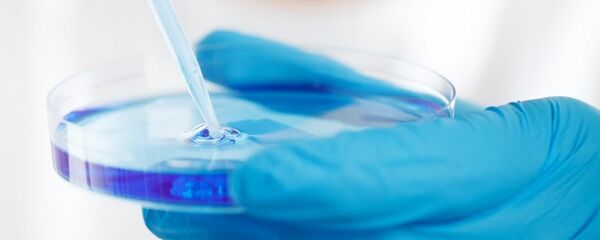
phòng thí nghiệm - Sputnik Việt Nam

Hôm qua 3.3, Cục Thú y Bộ NN-PTNT cho biết thống kê đến ngày 2.3, dịch tả lợn châu Phi đã xuất hiện ở 202 hộ chăn nuôi thuộc 7 tỉnh, thành phố gồm: Hưng Yên, Thái Bình, Hà Nội, Hải Phòng, Thanh Hóa, Hà Nam và Hải Dương.
Trong số đó, Hải Dương là địa phương mới nhất ghi nhận có dịch tả lợn châu Phi, xảy ra tại thôn An Thủy, xã Hiến Thành, H.Kinh Môn. Ông Nguyễn Minh Đức, Phó chi cục trưởng Chi cục Thú y Hải Dương, cho biết để tránh dịch bệnh lây lan diện rộng và đảm bảo an toàn cho 4.000 con lợn ở các hộ dân xung quanh, các đơn vị chức năng đã thành lập 3 chốt kiểm dịch. Ngay sau khi công bố dịch, UBND H.Kinh Môn đã yêu cầu tạm dừng các hoạt động mua bán, vận chuyển gia súc để tránh nguy cơ lây nhiễm cho các gia súc trong vùng có dịch và các sản phẩm ra vào vùng dịch.
Hội nghị trực tuyến chống dịch
Cũng theo thông tin từ Cục Thú y, ở các địa phương có dịch ghi nhận có 4.231 con lợn bị nhiễm bệnh phải tiêu hủy. Cục Thú y lấy 388 mẫu bệnh phẩm từ các đàn lợn xung quanh để phân tích xét nghiệm và đa số các mẫu xét nghiệm đều âm tính với vi rút.
Trước diễn biến phức tạp của bệnh dịch tả châu Phi đang có xu hướng lan rộng ở nhiều tỉnh, thành phố, trong hôm nay (4.3), Bộ NN-PTNT chủ trì hội nghị trực tuyến với các bộ, ngành và địa phương để triển khai các biện pháp cấp bách ngăn chặn và phòng ngừa bệnh dịch.
Hiện tại, Chính phủ đã có chính sách hỗ trợ người chăn nuôi với mức giá 38.000 đồng/kg cho số lợn phải tiêu hủy, nhưng thực tế, theo khảo sát của Cục Thú y, một số địa phương chỉ hỗ trợ được khoảng 27.000 đồng/kg và quy trình thủ tục kéo dài trong nhiều tháng.
Dự kiến tại hội nghị này, Bộ NN-PTNT sẽ kiến nghị Chính phủ có chính sách hỗ trợ người dân có lợn bị tiêu hủy bằng 80% giá thị trường, cắt giảm một số thủ tục để khuyến khích người dân thông báo khi đàn lợn dịch bệnh, không giấu dịch và bán chạy lợn bệnh để ngăn dịch lây lan.
Khuyến cáo khi mang thịt lợn vào Đài Loan
Ngày 3.3, Bộ Ngoại giao phát đi bản tin cảnh báo công dân về việc mang theo thịt lợn khi nhập cảnh vào Đài Loan, trong bối cảnh VN đã phát hiện dịch tả lợn châu Phi. Theo đó, sau khi VN thông báo chính thức phát hiện một số ổ dịch tại Hưng Yên và Thái Bình, Văn phòng Kinh tế và Văn hóa VN tại Đài Bắc cho biết Cục Kiểm dịch và phòng dịch động thực vật thuộc Ủy ban Nông nghiệp Đài Loan đã ra cảnh báo kể từ 0 giờ ngày 20.2, tất cả các du khách xuất cảnh từ VN khi nhập cảnh Đài Loan, nếu bị phát hiện mang theo các chế phẩm từ thịt lợn sẽ bị phạt hành chính lần đầu là 200.000 đài tệ (khoảng 140 triệu đồng); vi phạm lần 2 sẽ bị nâng mức phạt hành chính lên 1 triệu đài tệ (khoảng 700 triệu đồng). Trường hợp không nộp đủ tiền phạt sẽ bị cơ quan di trú Đài Loan từ chối cho phép nhập cảnh.
Bộ Ngoại giao cảnh báo: Trong thời gian tới công dân VN cần lưu ý và tuân thủ những quy định của Đài Loan để tránh phát sinh sự cố đáng tiếc. Để nhận được sự hỗ trợ trong trường hợp cần trợ giúp, công dân có thể liên hệ theo số đường dây nóng bảo hộ công dân của Văn phòng Kinh tế và Văn hóa VN tại Đài Bắc: +886988579362, hoặc số điện thoại của Tổng đài bảo hộ công dân: +84981 84 84 84.